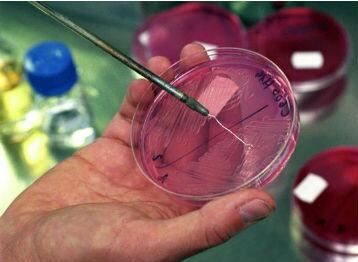
Sobre la tuberculosis, la evidencia científica encontró asociación específica para los eventos de salud y peor pronóstico de covid-19  para los pacientes con esta enfermedad, que es una patología infectocontagiosa causada por una bacteria denominada Mycobacterium tuberculosis o bacilo de Koch

Actualmente, Colombia se encuentra en la etapa III del plan de vacunación, en el que están varios sectores y diferentes grupos poblacionales, entre ellos personas entre los 55 y los 59 años, así como de los 16 a los 59 años con alguna de las comorbilidades fijadas por el Gobierno.

En principio, estaban las personas priorizadas por tener enfermedades como diabetes, hipertensión, obesidad, EPOC y otras, que desde que comenzó la pandemia se sabe que hacen a quienes las padecen más vulnerables frente al coronavirus, por ello fueron incluidos en esta etapa.
Ahora, con el decreto 630 del 9 de junio de 2021, el Gobierno añadió otras enfermedades para que las personas que tengan las siguientes patologías puedan ser incluidas en esta etapa que se está llevando a cabo. Estas son:
- Artritis reumatoide (M059, M069, J990, M051, M052, M053, M058, M060, M062, M063, M068).
- Lupus Eritematoso Sistémico (M329, M321)
- Espondilitis Anquilosante (M45X)
- Vasculitis (M052, M313, M301, M315)
Así las cosas, además de esas comorbilidades también están incluidas otras, que ya había dado a conocer el Gobierno, muchas incluso patologías mentales. Estas son:
- Enfermedades hipertensivas (110-115, 127.0, 127.2)
- Diabetes (E10-E14)
- Insuficiencia renal (N17-N19)
- VIH (820-824)
- Cáncer (COO-D48)

- Tuberculosis (A 15-A 19)
- EPOC (J44)
- Asma (J45)
- Obesidad Grado 1, 2 y 3 (Índice de Masa Corporal >30)
- En lista de espera de trasplante de órganos vitales
- Postrasplante de órganos vitales
- Enfermedad isquémica aguda del corazón (1248- 1249)
- Insuficiencia cardiaca (1500, 1501, 1509)
- Arritmias cardiacas (1470, 1490, 1498, 1499)
- Enfermedad cerebrovascular (1630-1639, 164X, 1678, 1679)
- Desórdenes neurológicos (G12, G12.2, G12.9, G 71.0, G20X, G35X, FOOO- F023, G800, G820- G825)
- Síndrome de Down (Q900-Q909)
- Inmunodeficiencia primaria (080-084)
- Esquizofrenia, trastorno esquizotípico y trastornos de ideas delirantes (F20-F29)
- Autismo (F84X)
- Trastorno bipolar (F31)
- Discapacidad intelectual (F70-F79) y otros trastornos mentales debidos a lesión, disfunción cerebral o enfermedad somática (F06)
- Fibrosis quística (E840-E849)
Sobre la tuberculosis, la evidencia científica encontró asociación específica para los eventos de salud y peor pronóstico de covid-19 para los pacientes con esta enfermedad, que es una patología infectocontagiosa causada por una bacteria denominada Mycobacterium tuberculosis o bacilo de Koch, la cual todavía existe y es prevalente en la población mundial.

“Esta enfermedad se transmite de persona a persona a través de pequeñas goticas o aerosoles que pueden quedar suspendidos en el aire hasta seis horas en ambientes cerrados no ventilados, cuando una persona enferma con tuberculosis pulmonar tose, estornuda o habla. Esta enfermedad puede afectar a cualquier persona independientemente de su edad, sexo, raza, estatus social o económico”, explicó Claudia Cuéllar, subdirectora de Enfermedades Transmisibles del Ministerio de Salud.
Actualmente, los pacientes con esta condición son priorizados en la etapa III del Plan Nacional de Vacunación dado el factor de riesgo que presentan y no existe ninguna contraindicación que les impida inmunizarse contra el nuevo coronavirus.
En Colombia se reportó al Programa Nacional de Prevención y Control de la Tuberculosis en el año 2020 un total de 12.744 casos de tuberculosis con una tasa de incidencia de 22.1 casos por cada 100 mil habitantes, representando una disminución frente a los 14.886 casos reportados en 2019. Dicha disminución en la detección de casos de esta comorbilidad se debe a la baja captación de sintomáticos respiratorios derivados del confinamiento de la población y baja consulta a los servicios de salud.
¿Vacunación masiva?
Como se sabe, en esta etapa y la siguiente, es decir la cuarta, se priorizan personas o poblaciones como privada de la libertad que esté cumpliendo su condena o medida de aseguramiento en la modalidad intramural, incluyendo la del sistema de responsabilidad penal en entorno institucional, de 16 años o más.
También estarán incluidos habitantes de calle, bomberos activos en el país, pilotos y auxiliares de vuelo, entre otros.
Sin embargo, Germán Escobar, jefe de Gabinete del Ministerio de Salud, aseguró que la fase cuatro es muy corta, por lo que a principios de julio podría estar adelantándose la fase cinco, que implica una vacunación masiva. De acuerdo con el mencionado decreto, en esta etapa “se vacunará a la población de 12 años y más que no se encuentre en las poblaciones indicadas en las etapas, 1, 2, 3 y 4. Se mantendrá el orden de aplicación comenzando con los adultos entre 30 y 39 años, hasta llegar a los jóvenes y adolescentes”.
